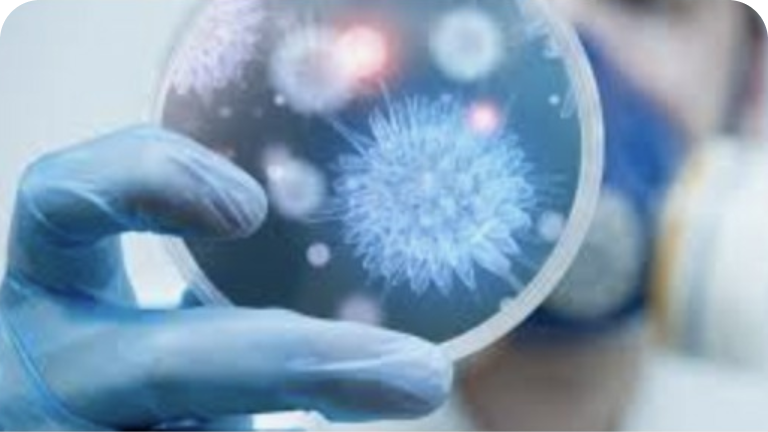
_Feature text (style)@2x

SFN10 is formulated with Ethyl Lactate, Acetic Acid and Undecylenic Acid – a combination that creates an undesirable environment for fungi to spread by rapidly killing the common fungi,
A. niger, C. albicans and T. rubrum.

The SFN10 topical treatment for nail mycosis comes with a specially-designed applicator. The patented micro bristle tip gives you a mess-free application while delivering maximum efficacy and consistent dosage that helps penetrate deep into the nail bed.

The most common infection of nail mycosis is caused by mould, yeast and dermatophytes that invade the nails. SFN10 uses Wide Spectrum Therapy in order to target and treat a variety of nail fungi to heal your nails and return them to their shiny, healthy look!